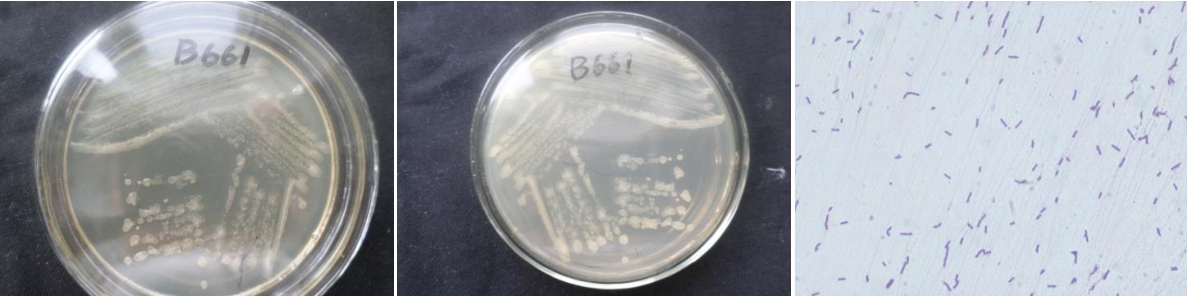

Loading...
| StrainNO | B661 |
| Classification | Bacillus |
| 16s rDNA sequence | ACTTCTTGTTCACCTTCGGCGGCTGGCTCCAAAAGGTTACCTCACCGACTTCGGGTGTTACAAACTCTCGTGGTGTGACGGGCG GTGTGTACAAGGCCCGGGAACGTATTCACCGCGGCATGCTGATCCGCGATTACTAGCGATTCCAGCTTCACGCAGTCGAGTTGC AGACTGCGATCCGAACTGAGAACAGATTTGTGGGATTGGCTTAGCCTCGCGGCTTCGCTGCCCTTTGTTCTGCCCATTGTAGCA CGTGTGTAGCCCAGGTCATAAGGGGCATGATGATTTGACGTCATCCCCACCTTCCTCCGGTTTGTCACCGGCAGTCACCTTAGA GTGCCCAACTGAATGCTGGCAACTAAGATCAAGGGTTGCGCTCGTTGCGGGACTTAACCCAACATCTCACGACACGAGCTGACG ACAACCATGCACCACCTGTCACTCTGCCCCCGAAGGGGAAGCCCTATCTCTAGGGTTGTCAGAGGATGTCAAGACCTGGTAAGG TTCTTCGCGTTGCTTCGAATTAAACCACATGCTCCACCGCTTGTGCGGGCCCCCGTCAATTCCTTTGAGTTTCAGTCTTGCGAC CGTACTCCCCAGGCGGAGTGCTTAATGCGTTTGCTGCAGCACTAAAGGGCGGAAACCCTCTAACACTTAGCACTCATCGTTTAC GGCGTGGACTACCAGGGTATCTAATCCTGTTCGCTCCCCACGCTTTCGCGCCTCAGCGTCAGTTACAGACCAGAGAGTCGCCTT CGCCACTGGTGTTCCTCCACATCTCTACGCATTTCACCGCTACACGTGGAATTCCACTCTCCTCTTCTGCACTCAAGTTCCCCA GTTTCCAATGACCCTCCCCGGTTGAGCCGGGGGCTTTCACATCAGACTTAAGAAACCGCCTGCGCGCGCTTTACGCCCAATAAT TCCGGACAACGCTTGCCACCTACGTATTACCGCGGCTGCTGGCACGTAGTTAGCCGTGGCTTTCTGGGTAGGTACCGTCAAGGT ACCGCCCTATTCGAACGGTACTTGTTCTTCCCTAACAACAGGAGATTA |
| Strain Morphology Photos | |
| Morphological Description | round;clam white;edge neatly;edge bumps;middle flat;multi-fold;slippy;sticky;waxy;Rod;having spore;bias in budding spores |